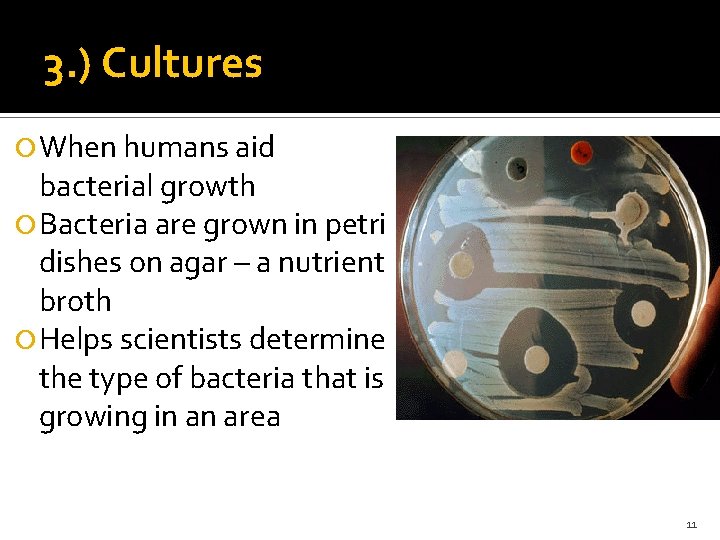
3. ) Cultures When humans aid bacterial growth Bacteria are grown in petri dishes

Bacteria 1 A 2 types Eubacteria True Bacteria

Bacteria 1

A. 2 types: Eubacteria (True Bacteria) Archaebacteria (Ancient) 2

B. Bacteria Features: Microscopic Prokaryotes No Nucleus No membrane bound organelles 3

More structures that all bacteria have: Cell wall Cell membrane Cytoplasm DNA 4

C. Bacteria Shapes Cocci sphere Streptococci chains of spheres Staphylococci clusters of spheres 5

More Shapes Bacilli Rod Shaped Spirilla Spiral or curly 6

7

D. Harsh conditions survived through: Capsules slime layers that help bacteria evade immune system Endospores structure dormant 8

E. Movement: Flagella long whiplike structure (few) Cillia short hair like structures (many) 9

F. Reproduction 1. )Binary Fission asexual reproduction; bacteria duplicates into two 2. )Conjugation sexual reproduction by using pili Pili = hair like projections that help exchange DNA 10
3. ) Cultures When humans aid bacterial growth Bacteria are grown in petri dishes on agar – a nutrient broth Helps scientists determine the type of bacteria that is growing in an area 11

G. Antibiotics History 1 st to discover antibiotics? ? ? Alexander Fleming PENICILLIN HOW? ? By accident with bread and fungi 12

Nobel Prize Later Howard Flory received the Nobel Prize for Penicillin 13

ANTISEPTICS Kills or inhibits bacterial growth Applied directly to skin Exs: Neosporin, Alcohol ANTIBIOTICS Drugs taken orally that kill BACTERIAL INFECTIONS Exs: Amoxicillin, Pennicilin, Zithromax, 14

Virus 15

General Facts N o K g i n n i g v d i o l m n No No Cells 16

A. Structure Made up of nucleic acids Either DNA or RNA 17

Structure (cont’d) Capsid – protein coating surrounding the nucleic acid Ex. Stomach Virus, Naked Envelope: made of lipids and is outside of the capsid EX. HIV, Flu, Chicken Pox 18

B. Intracellular Parasites Obligate Intracellular parasite Goes into a cell, replicates, and kills host RNA Viruses known as Retrovirus THE WORST Retroviruses have reverse transcriptase: when RNA begins making DNA and then replicates and mutates 19

C. Replication of Virus What kind of host cell? Bacteriophage – virus that infect bacteria and is virulent (fast acting) Ex. Stomach flu 20

Bacteriophage 21

Reproduction (cont’d) Lytic Cycle – virulent; makes new virus quickly Lysogenic Cycle –temperate or dormant stage; incubates until conditions are tolerable Ex. Herpes, HIV 22

D. Subcellular Particles Not viruses Viroids – smallest particle to replicate, has no capsid, and affects plants Ex. Potato Blight, Orange Blight 23

D. Subcellular Particles Prions – an abnormal form of protein that infects animals Ex. Scrapie, BSE (mad cow disease), Kuru 24

Full words of Abbreviations Bovine Spongiform Encephalopathy BSE Escherichia coli 25
- Slides: 25